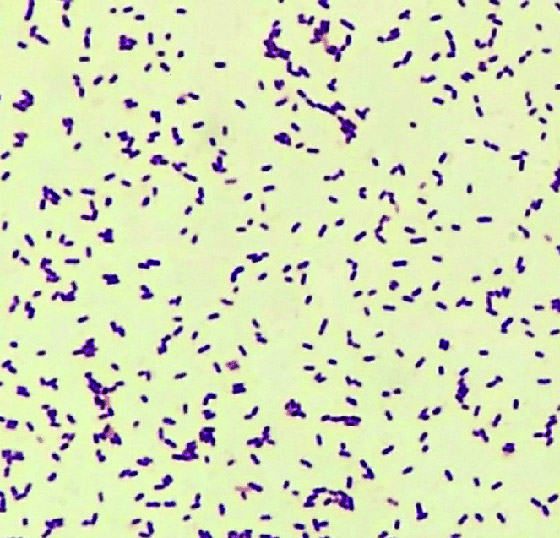

وجهت السلطات الصحية البريطانية تنبيها إلى الحوامل بالابتعاد عن تناول بعض الأطعمة، بسبب تسجيل إصابات أكبر من الطبيعي بعدوى الليستريا. وعدوى الليستريا مرض بكتيري منقول بالغذاء قد يكون خطيرا جدا على المرأة الحامل، والأشخاص الذين تزيد أعمارهم على 65 عاما والأشخاص المصابين بضعف أجهزة المناعة.

وتحدث الإصابة في الغالب نتيجة تناول لحم خاصرة غير المعالج ومنتجات الحليب غير المبسترة، بحسب موقع عيادة أمريكي على الإنترنت. وتظهر أعراض عدة على المصابين بهذه العدوى، منها الحمى والغثيان والإسهال، وتتمثل خطورتها على الحوامل بأنهن يجهضن تلقائيا إثر الإصابة بها.

وذكرت صحيفة بريطانية أنه تم ربط التفشي الكبير لعدوى الليستريا بتناول السمك المُدخن. وأضافت أن الخبراء يحثون الناس على طهي السمك المُدخن جيدا قبل تناوله. وقالت الصحيفة إن الحوامل في بعض مناطق بريطانيا تلقين رسائل نصية تحذر من هذه العدوى.